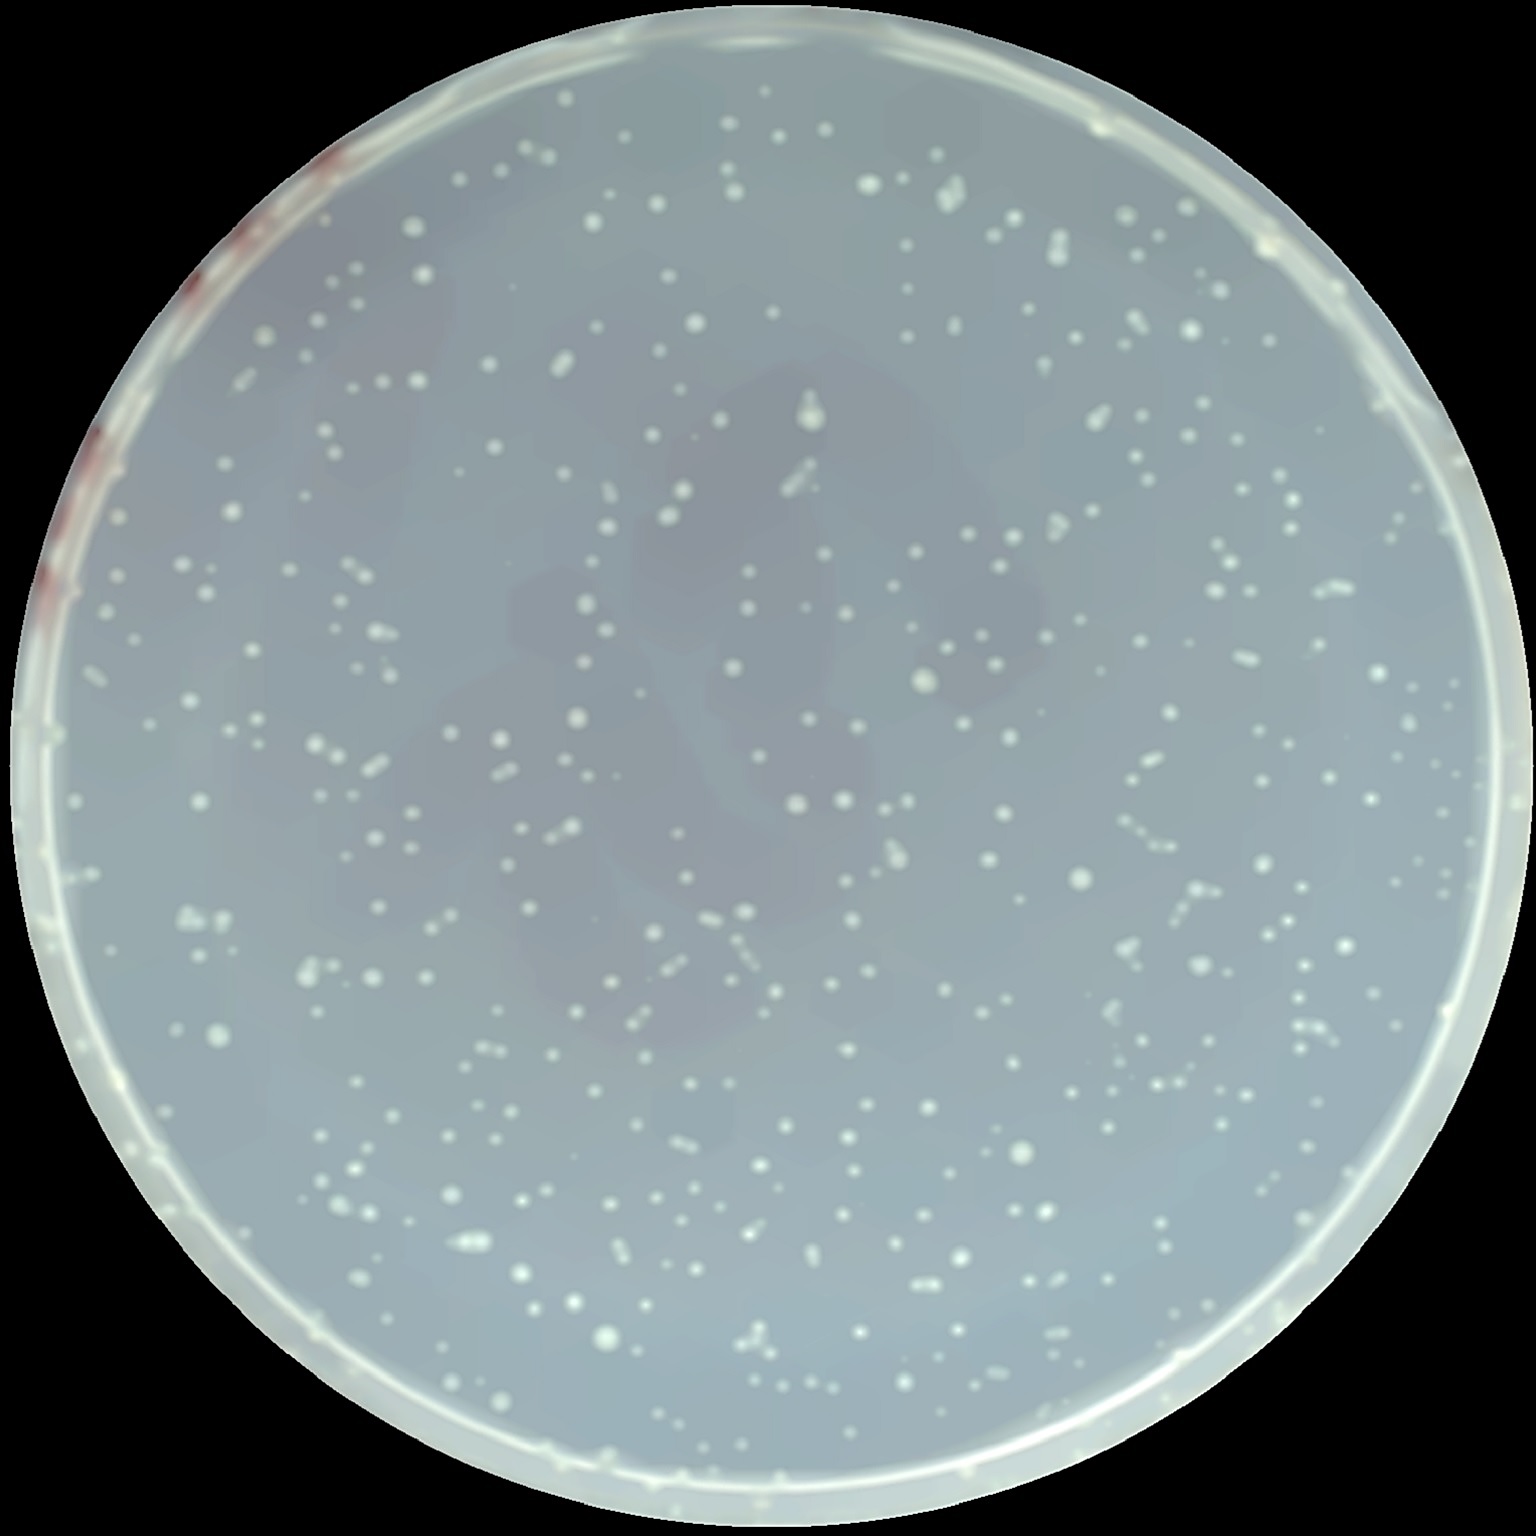
コロニーカウンター（CC500）｜ヤマト科学株式会社

【再入荷!】 コントラスト コロネード5点セット コロネード5点セット コントラスト 食器
(3032件)
Pontaパス特典
サンキュー配送
12180円(税込)
122ポイント(1%)
Pontaパス会員ならさらに+1%ポイント還元!
送料
(
)
3022
配送情報
お届け予定日:2026.04.19 12:0までにお届け
※一部地域・離島につきましては、表示のお届け予定日期間内にお届けできない場合があります。
ロットナンバー
55131156199
お買い物の前にチェック!

Pontaパス会員なら
ポイント+1%
ポイント+1%
商品説明
ウェッジウッド コントラストコロネードのカップ&ソーサー2客とグレービーボート.シュガーポット.クリーマーの5点セットです。食器としての使用は無く、キャビネットに長く飾っておりました。艶もあり綺麗です。使ってくださる方よろしくお願い致します。カップ︰口径8.5cm 高さ6cmソーサー:直径14cm 高さ2cmグレービーボート:最長18cm 高さ8.5cmグレービーボートソーサー:最長21.5cm 高さ2cmシュガーポット:最長10cm 高さ8cmクリーマー:最長13cm 高さ7.5cm| カテゴリー: | キッチン・日用品・その他>>>食器>>>食器セット |
|---|---|
| 商品の状態: | 未使用に近い","数回使用し、あまり使用感がない |
| ブランド: | |
| 配送料の負担: | 送料込み(出品者負担) |
| 配送の方法: | 佐川急便/日本郵便 |
| 発送元の地域: | 未定 |
| 発送までの日数: | 1~2日で発送 |
レビュー
商品の評価:




 4.4点(3032件)
4.4点(3032件)
- ごん6811
- しっかりした作りでとても良い商品でした。 発送も早かったです。
- チャーミー74
- 適時発送頂きました。 サイズも良く満足です。 またお願いしたいです。
- Y9999
- サイズはもう少し小さいイメージだったので、何種類か求めましたが、予めスペアを求めたことにします。
- mm11503745
- サイズはもう少し小さいイメージだったので、何種類か求めましたが、予めスペアを求めたことにします。
- 東限
- サイズはもう少し小さいイメージだったので、何種類か求めましたが、予めスペアを求めたことにします。
- ahaiai
- サイズはもう少し小さいイメージだったので、何種類か求めましたが、予めスペアを求めたことにします。
- ラッキー964756
- アウトレット商品とは思えない良い状態の商品なので、こんなにお安くてよいのかしらと思いました。
- kyon725
- アウトレット商品とは思えない良い状態の商品なので、こんなにお安くてよいのかしらと思いました。
- にゃんぽぽ36
- ぶっかけうどんの時に使いました。 小振りで使い勝手もいいです。 和だけでなく、色々なジャンルに使えそうです。
- jihad0
- 完全に衝動買いでした。そばちょことおそろいだったので購入。つけだれの追加分を入れるくらいで最初からでは小さいです。でも、シルエットがかわいいので、そばつゆにかぎらず、牛乳入れてコーンフレーク…とか別の使い方も考えてみたいです。花瓶にしてもかわいいかな。
- ふりみしゃん
- さっそく使ってみました。 入っていた小さな商品説明には予め冷やしたお酒を徳利に入れて下さい、とありましたが、 急に夕食で飲むこととなり常温の日本酒を入れてポケットに氷。 常温のためポケットの氷との温度差がありすぎて徳利の表面に水滴がかなり付着し水滴をかなり拭き取りました。このことを防ぐために予め冷やしたお酒を、と書かれているのでしょうね。 急に飲むことになったら仕方がないと思ってます。ポケットの氷で薄まることも無く、キンキンに冷えてとても美味しく日本酒頂けました。とても満足です。 ありがとうございました。
- mikamix25
- 注文から発送まで早くて、とても助かりました。 品薄の商品なので、良かったです。
すべて見る
お店の情報
7,367
連絡・応対
4.3
配送スピード
4.3
梱包
4.3